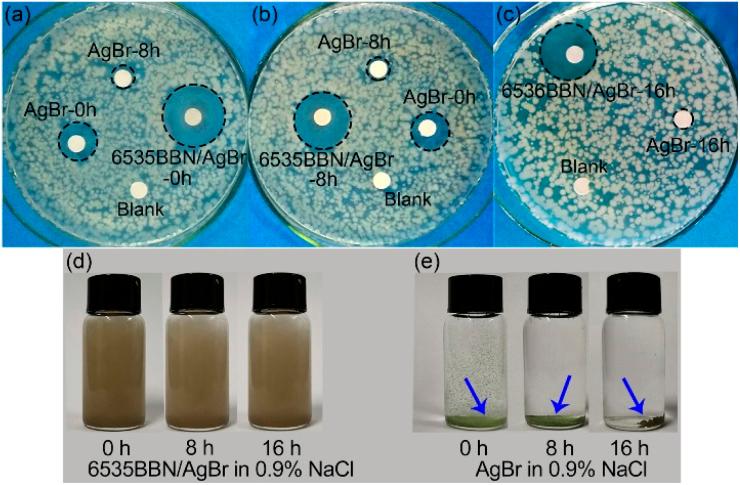
https://cdn.ncbi.nlm.nih.gov/pmc/blobs/1f30/9811651/34497def5248/d2ra07447h-f6.jpg

BiO(OH)(NO)·2HO/AgBr复合材料的制备及其长效抗菌效果。
Preparation of a BiO(OH)(NO)·2HO/AgBr composite and its long-lasting antibacterial efficacy.
作者信息
Zhao Mei, Liu Mengchen, Yao Jinfeng, Li Wenyu, Li Chengdong, Zhang Qian, Zhang Zhihua, Wang Wenjun
机构信息
College of Materials Science and Engineering, Qingdao University of Science and Technology Qingdao 266042 China.
School of Materials Science and Engineering, Dalian Jiaotong University Dalian 116028 China.
出版信息
RSC Adv. 2023 Jan 4;13(2):1216-1222. doi: 10.1039/d2ra07447h. eCollection 2023 Jan 3.
A novel BiO(OH)(NO)·2HO/AgBr (6535BBN/AgBr) composite with long-lasting antibacterial efficacy was prepared. The microstructure of the composite was characterized. AgBr nanoparticles (NPs) were sandwiched in 6535BBN nanosheets (NSs) or loaded on their surfaces. The utilization of 6535BBN as carriers contributed to the long-term lasting antibacterial activity of the composite after storage in water or 0.9% NaCl. The antibacterial activity was evaluated by inhibition zones against . The inhibition zone diameters of 6535BBN/AgBr stored in water for 0 h, 8 h, 16 h, and 48 h were measured as 22.50, 21.71, 20.43, and 20.29 mm, respectively. The activity of the composite after storage in water for 48 h remained 90.2% of that in the beginning. After storing in 0.9% NaCl for 16 h, the activity was determined to be 90.1% of that in the beginning. In comparison with the rapid decrease in the antibacterial activity of pure AgBr, the slow reduction of 6535BBN/AgBr after storage indicates long-lasting efficacy. The excellent dispersion states of 6535BBN/AgBr powders after storage in solutions were revealed, and the positive relationship between the dispersion state and its long-lasting antibacterial activity was suggested. Based on the unique load-on-carrier (LOC) structure, the long-lasting antibacterial performance was promoted by the synergy of the sharp-edge-cutting effect of 6535BBN NSs, prolonged ROS antibacterial effect, and restrained sterilization effects of silver ions caused by their slow release.
制备了一种具有长效抗菌效果的新型BiO(OH)(NO)·2HO/AgBr(6535BBN/AgBr)复合材料。对该复合材料的微观结构进行了表征。AgBr纳米颗粒夹在6535BBN纳米片中或负载在其表面。6535BBN作为载体的利用有助于复合材料在水中或0.9% NaCl中储存后具有长期持久的抗菌活性。通过对……的抑菌圈来评估抗菌活性。测定了6535BBN/AgBr在水中储存0 h、8 h、16 h和48 h后的抑菌圈直径分别为22.50、21.71、20.43和20.29 mm。在水中储存48 h后,复合材料的活性仍为初始活性的90.2%。在0.9% NaCl中储存16 h后,活性测定为初始活性的90.1%。与纯AgBr抗菌活性的快速下降相比,6535BBN/AgBr储存后的缓慢下降表明其具有长效功效。揭示了6535BBN/AgBr粉末在溶液中储存后的优异分散状态,并提出了分散状态与其长效抗菌活性之间的正相关关系。基于独特的载体负载(LOC)结构,通过6535BBN纳米片的锐边切割效应、延长的ROS抗菌效应以及银离子缓慢释放引起的杀菌效应的协同作用,促进了长效抗菌性能。